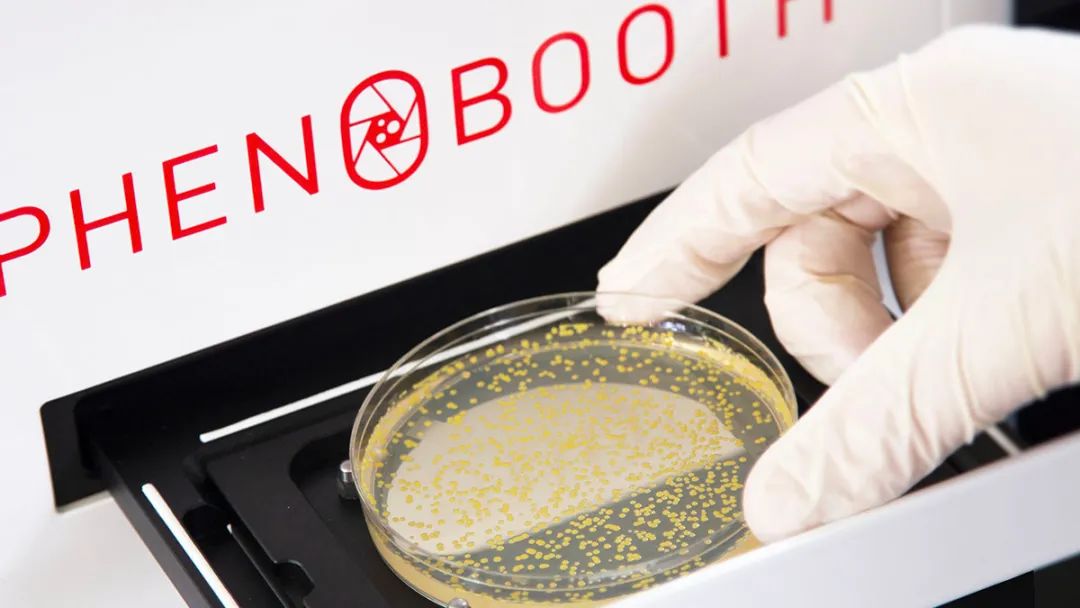

新聞應用
更新時間:2024-09-25 瀏覽次數(shù):392
近日,英國SINGER公司發(fā)起一項活動,評選有創(chuàng)意的菌落影像,有機會免費擁有世界高分辨率的彩色菌落分析系統(tǒng)PhenoBooth+。
參與通道:https://www.singerinstruments.com/the-singer-bioart-competition/

大腸桿菌的菌落計數(shù)很容易。但是如果你需要計數(shù)不規(guī)則半透明的菌落,同時又要排除圓形的黃色菌落,這無疑是個艱巨的工作。除非你有它……

簡介
PhenoBooth+是一種快速、易于使用的暗室菌落計數(shù)儀,能對瓊脂上的菌落進行成像和分析;采用科學級相機,可產(chǎn)生2300萬像素的平皿圖像。還包括五個照明通道,可獲得圓形或矩形培養(yǎng)皿中的高分辨率菌落圖像。
原理
將帶有細菌、酵母或其他微生物的培養(yǎng)皿放入托盤中,選擇光源,儀器會自動對焦并在幾秒鐘內(nèi)獲得培養(yǎng)皿圖像;然后自定義篩選條件,點擊“批量分析”,通過PhenoBooth+即可自動完成所有培養(yǎng)皿上的菌落分析。
在自定義篩選條件中,可按照菌落的大小、顏色、圓度和亮度進行篩選。應用包括菌落計數(shù)、生長曲線和熒光(BFP/GFP/YFP/mCherry*)檢測。

上圖是PhenoBooth+直接輸出的300%放大倍數(shù)的釀酒酵母菌落圖片,未經(jīng)后期處理??梢跃_的捕獲培養(yǎng)皿中的所有菌。
PhenoBooth+提供兩種照明方式:透射(后)光用來大化菌落和背景之間的差異度,而入射(頂部)光則可以捕獲顏色。PhenoBooth+配備了多種光源,來篩選所需的熒光;內(nèi)部光源包括白色、藍色、紫色和青色。
紫色:50%的強度范圍為375 – 400nm,峰值約為390nm。
藍色:50%的強度范圍為465 – 475nm,峰值為470nm。
青色:50%的強度范圍為490– 530nm,峰值為510nm。


功能
全面的表型分析——可以按大小、顏色、圓度和亮度篩選菌落
獲得佳結果——高品質照明和成像,可實現(xiàn)佳分析
分析任何內(nèi)容——從4通道SpectraStar?光源中任選一個:白色、藍色、青色和紫色或1個透射照明通道。適配標準的25mm發(fā)射光濾光片進行熒光檢測
節(jié)省時間——一鍵處理和分析數(shù)百個圖像
用途廣泛——可以檢測到每個菌落,即使是在6,144密度的菌落陣列上進行檢測
面向未來的實驗室——特定應用程序的軟件包(例如菌落篩選或菌落挑選)與其他高級功能設備無縫集成。
PhenoBooth+、Rotor——高通量菌落篩選工作站
菌落高通量篩選工作站由PhenoBooth+,Rotor HDA和Stinger組成。使用PhenoBooth+對隨機排列的菌落進行成像分析,然后使用Colony Picking功能篩選感感興趣的菌落??梢詫⒕渥鴺藢С霾⒓虞d到Rotor HDA篩選機器人中,然后由Stinger單菌落挑取模塊將其排成陣列。

資源
關于我們
聯(lián)系我們

?2024 上海磐麥科技有限公司 版權所有 備案號:滬ICP備20012062號-3